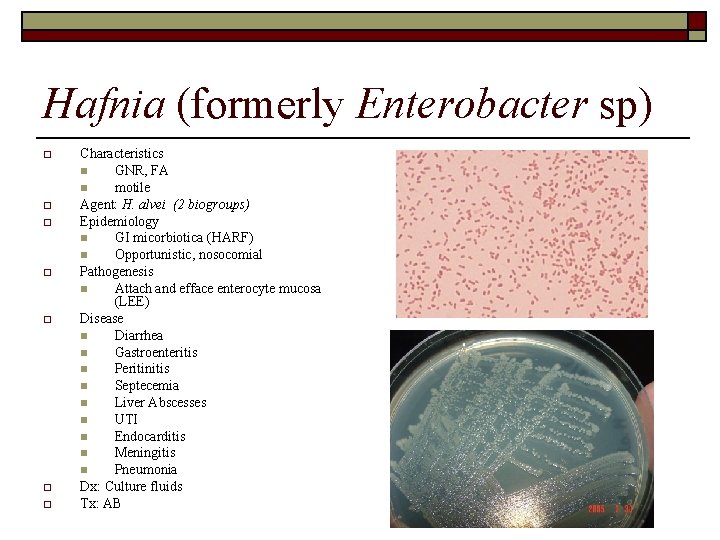
Hafnia (formerly Enterobacter sp) o o o o Characteristics n GNR, FA n motile

Gram Negative Bacterial Diseases Proteobacteria o Alpha Parasitic

Gram Negative Bacterial Diseases

Proteobacteria o Alpha: Parasitic bacteria n n o o Beta: GNC Gamma n n o Largest group Enterics Delta n n o Tick borne diseases Flea vector Sulfur reducing bacteria in soil/water Predatory (attack other bacteria) Epsilon : GI

Gram Negative Cell Wall

Neisseria o Characteristics n n o GNC, diplococci Capnophile Nonmotile Oxidase (+) Pathogenicity n n Fimbria Capsule Protease (inhibit Ig. A) LOS (oligosaccharide) o Lipid A endotoxin

Neisseria meningitidis o Epidemiology n o Pathogenicity n n n o o Various strains Capsule LOS: lipid A Disease n o Normal microbiotica (resp) meningitis Septicemia/death Dx: CNS, Ab Tx: AB Prevention n n Vaccination Prophylactic AB to exposed

Neisseria gonorrhoeae o o o Gonococci n Eye n Pharynx n Uritogenital n Rectum Pathogenicity n Adhesins o Pili o Protein II n Replicate in WBCs Disease n STD “Clap” n PID scar tissue n Neonatal conjunctivitis n Inflammation o Urinary o Repro o Oral Cavity

Neisseria gonorrhoeae o Dx n n o Culture/Isolation Symptoms Tx: n AB Cephao quinolones n Iodine/Silver Nitrate (eye) Prevention: n Screen/Detection n Tx infected individuals n Condom use n Public education o o

Enterobacteriaceae o o Characteristics n GNR n Motile = flagella n Capsule/slime layer n Nitrate reduction n FA n Oxidase (-) Epidemiology n Source o GI o Water o Soil o Decaying vegetation Gamma Proteobacteria

Enterobacteriaceae o Groups n Gammaproteobacteria: Enterics o Coliforms o Noncoliforms o Pathogens n FA n Oxidase (-) n Reduce nitrate n (cocco)bacilli

Enterobacteriaceae o Pathogenicity n LPS o o o n Antigens o o n Core polysaccharide O polysaccharide Lipid A endotoxin Capsular (K) Flagellar (H) Virulence factors o Immune evasion n o o Capsule Fimbriae Type III secretion system Adhesins Exotoxins Hemolysins Iron-binding compounds

Enterobacteriaceae o Dx n Culture/Isolation o o n o Location Tx n n o MAC EMB Supportive AB Prevention n n Hand washing Sewage control

Coliforms o o Normal GI microbiotica Groups n n n o Escherichia Klebsiella Serratia Enterobacter Hafnia Citrobacter Biochemical tests n Ferment lactose

Enteric Bacteria o Pathogenicity n n Glycocalyx LPS o o o n n n n n Core polysaccharide O antigen Lipid A endotoxin K (capsular) antigens H (flagellar) antigens Fimbria Adhesins Exotoxins Hemolysins Bacteriocins Iron binding proteins Sex Pili AB resistance

Enteric Bacteria o Diagnosis n n o Treatment n n o Culture Biochemical tests AB Toxin neutralization Prevention n n Hygiene Clean water supply

Esherichia coli o o o Coliform n E. coli O 157: H 7 Pathogenicity n O, H, K antigens n Plasmids for virulence n Shiga-like Toxin n Type III secretion system o Disrupt PM o Receptors for attachment Diseases n Gastroenteritis o Food-fecal contamination n UTI o Uremic syndrome o Pyelonephritis n Septicemia n Neonatal meningitis

Klebsiella o Epidemiology n n Nosocomial Reservior o o Pathogenicity n o Polysaccharide capsules Diseases n n UTI Bacteremia Meningitis Pneumonia o o o Soil, water GI Respiratory tract Cherry red sputum Lung abscess Empyema Dx: Culture Tx: AB

Serratia o Characteristics n n o o Red pigment coliform Agent: S. marcescens Epidemiology n Nosocomial o o n n o GI Soil, water Pathogenicity n n o Opportunistic Fomites (catheters, saline solutions) AB resistance Endotoxin Diseases n n UTI URTI

Enterobacter o o o Agents n E. aerogenes n E. cloacae Location n Coliform n Water, sewage n Soil Epidemiology n Opportunistic o Blood o Wounds/incisions n Nosocomial Pathogenicity n Endotoxin n AB resistance Disease n Dairy contaminant n UTI n Pneumonia
Hafnia (formerly Enterobacter sp) o o o o Characteristics n GNR, FA n motile Agent: H. alvei (2 biogroups) Epidemiology n GI micorbiotica (HARF) n Opportunistic, nosocomial Pathogenesis n Attach and efface enterocyte mucosa (LEE) Disease n Diarrhea n Gastroenteritis n Peritinitis n Septecemia n Liver Abscesses n UTI n Endocarditis n Meningitis n Pneumonia Dx: Culture fluids Tx: AB

Citrobacter o o o o Characteristics n GNR, FA n Ferment lactose Agent: C. freundii Epidemiology n GI microbiotica (HARF) n Soil, water n Decaying vegetation Pathogenesis n Opportunistic n Lipid A endotoxin Disease n UTI n Cholecystitis n Meningitis n OM Dx: Culture fluids Tx: AB

Noncoliform o o o Opportunistic Nosocomial Diseases n UTI n Kidney stones Groups n Proteus n Morganella n Providencia n Edwardsiella Biochemical n Non lactose fomenters

Proteus o Characteristics n n n o Agent n n o Urease Motility Endotoxin Disease n o Colon, soil & water Opportunistic Pathogenicity n o P. mirabilis P. vulgaris Epidemiology n o GNR, FA Flagella (polar), swarms Urease (+) UTI (catheter) Kidney stones Dx: Culture Tx: AB, resistance is developing

Morganella (formerly Proteus sp. ) o Characteristics n n o Agents n o n n n o GI microbiotica (HAR) Nosocomial Pathogenesis: Lipid A endotoxin Disease n o M. morganii Epidemiology n o GNR, FA, motile Only glucose fermentation UTI GI diarrhea CNS infection Ear and Sinus infections Dx: Culture Tx: AB

Providencia o o o Characteristics n GNR n Motile n FA Agents: n P. stuartii n P. rettgeri n P. alcalifaciens Epidemiology n Normal GI microbiotica o o Nosocomial o Catheter o Endotracheal tubes Pathogenesis: plasmid codes for urease Disease n GU: UTI, prostatitis, kidney stones n Pneumonia n Bacteremia Dx: Culture fluids, feces Tx: AB, but developing resistance n o o animals humans

Edwardsiella o Characteristics n n o Agents n n o Opportunistic GI tract (HARF) Pathogenesis Disease n o E. hoshinae E. tarda Epidemiology n o GNR, FA +/- motility Gastroenteritis UTI Wound infections Dx: Culture fluids Tx: AB

Pathogenic Enteric Bacteria o Characteristics n n NLF Virulence o o o Type III secretion Toxins Groups n n n Salmonella Shigella Yersinia

Salmonella o o o Characteristic n GNR n Motile (peritrichous) n Gas production n H 2 S production n Urease (-) n Oxidase (-) Location n GI (S. enterica) n 2, 000 serovars Examples n S. typhi n S. paratyphi n S. typhimurium

Salmonella pathogenicity o o o Epidemiology n Fecal contamination n Poultry products n Milk Pathogenicity n Many serotypes n Proteins endocytosis n Invade intestinal mucosa n Toxins o Enterotoxin o Cytotoxin Diseases n Salmonellosis o N/V/D o Bacteremia n Typhoid fever o Gastroenteritis o Bacteremia o Peritonitis

Salmonella o Dx n n n o Tx Supportive n AB n Cholecystectomy Prevention n Hygiene n Proper food handling o Cooking o Refrigeration n Vaccination n o Culture Isolation Symptoms

Salmonella typhi o o o Epidemiology n Source o Carrier’s feces n Transmission o Contaminated food/H 2 O Pathogenesis n Invade GI spread to LN, Liver, GB n Shed bacteria in feces: 3 mos n Abdominal pain, anorexia Disease n Typhoid fever Dx: Culture blood, feces; Serology Tx: AB Prevention: n Food handling n Isolation of infected individuals n Vaccine for high risk individuals

Shigella o Characteristics n n o GNR Nonmotile FA (-): urease, oxidase Examples n n S. dysenteriae S. flexneri S. boydii S. sonnei

Shigella o Location n GI pathogen o Epidemiology n Source: food/water contamination with feces n Transmission o Fecal-oral o 4 F’s n n food fingers feces flies

Shigella o o o Pathogenesis n Multiply in colon mucosa n Disrupt phagosome membrane and invade n Toxins o Exotoxin: Shiga Toxin o Endotoxin Disease n Diarrhea: o water, blood, mucus o Shigellosis dysentery n Ulcerate colon Dx: Isolates, biochemical tests, serology Tx: fluid support, AB Prevention n Hygiene n Sewage treatment

Yersinia o Characteristics n o Location n n o GNR GI of animals Endemic (in West Texas) Epidemiology n Food/H 20 contamination with feces o o n o Direct contact Indirect: inhalation Vector: flea bite Agents n n n Y. enterocolitica Y. pseudotuberculosis Y. pestis

Yersinia o Pathogenicity n n n Pathogen YOPS o outer membrane proteins o Prevent phagocytosis Plasmid virulence factors o o Adhesins Type III secretion systems n Trigger apoptosis o PMN o MO

Yersinia o Diseases n Gastroenteritis (Y. enterocolitica) o SI o Mesenteric LN n Plague (Y. pestis) o Bubonic (LN) o Pneumonic (Lungs) o Dx: Blood ID, culture, PCR Tx: AB Prevention: control n Rodent n Flea n Vaccination n Isolation of infected persons o o

Plague life cycle o Reservoir n n n o o Rats Mice Voles Vector: Flea Hosts n Amplify o o o Prairie dogs Rabbits Deer Dogs/Cats Cycle n n Flea bite Exposure to infected animals

Bubonic Plague o o o Lymphadenopathy Bacteremia DIC S. C. Hemorrhage Gangrene “Black” Death

Pneumonic Plague o Lungs n n o Bloody sputum Dyspnea Respiratory droplet

Alpha, Beta, & other Gamma proteobacteria o o o Aerobic GNR Groups n n n Alpha o Bartonella o Brucella Beta o Bordetella o Burkholderia Gamma o Pseudomonads n Pseudomonas n Moraxella n Acinetobacter o Francisella o Legionella o Coxiella

Alpha Proteobacteria

Bartonella o Characteristics n o o o Aerobic Location: animals Vectors: insects Examples n n n B. bacilliformis B. quintana B. henselae

Bartonella Diseases o Bartonellosis n n o Trench fever n n o Lice Bone pain Bacillary n n o Sand flies RBCs invaded Angiomatosis Peliosis hepatitis Cat-Scratch fever n n n fleas Cat nails, teeth LN and abscesses

Brucella o Characteristics n o Location n n o Intracellular parasite Animal hosts Pathogenicity n o coccobacillus Prevent phagolysosome Examples n n B. melitensis B. abortus B. suis B. canis

Brucella o Epidemiology n n n o Disease n o o Unpasteurized dairy Animal blood / urine Reproductive organs Undulant fever (Bangs) Tx: AB Prevention n Animal vaccination

Beta Proteobacteria

Bordetella o Characteristics n n o o Aerobic GN coccobacillus Location Examples n n n B. pertussis B. parapertussis B. bronchiseptica

Bordetella o Epidemiology n n o Inhaled aerosols Inhibit ciliary action Pathogenicity n n Adhesins Toxins o o o Pertussis Adenylate cyclase Dermonecrotic Tracheal Disease: whooping cough Prevention n n Hygiene Vaccination (DPT)

Burkholderia o o Characteristics n Aerobic n Flagella Location n environmental n Opportunistic: o Lungs o Joints o Skin Diseases n Meliodosis n Glanders Example n Burk. cepacia n Burk. mallei n Burk. pseuodomallei

Gamma Proteobacteria

Pseudomonads o Characteristics n n o Location n o GNR aerobic Environment: soil Moist areas opportunistic Examples n n n Pseudomonas Moraxella Actinobacter

Pseudomonas aeruginosa o Pathogenicity n n n Fimbria= biofilms Adhesins Enzymes o o n n Neuraminidase elastase Capsule ROS Drug Antiports Toxins o o Endotoxin: Lipid A Exotoxin n n Exotoxin A Exoenzyme S

Pseudomonas aeruginosa o Diseases n n n n Bacteremia Endocarditis UTI CNS GI M/SK Burn Resp

Moraxella catarrhalis (formerly Branhamella sp) o Characteristics n n o Aerobic Short bacilli Disease n n Opportunistic URTI Ears Sinusitis

Acinetobacter o Characteristics n n o Location n o Aerobic Short bacillus Soil Water Sewage Diseases n n n Opportunistic URTI UTI CNS Endocarditis

Francisella o o o Characteristics: GNR Agent: F. tularensis Epidemiology n Animal reservoirs (rabbits) n Transmission o Vector bite (tick, fly, mosq) o Direct contact with infected tissue o Inhalation Pathogenesis n Ulcer n Enlarged LN Disease n o o o Tuleremia Dx: Culture, PCR, Florescent. Ab/Agglut Tx: AB Prevention n Vector control n Vaccination

Francisella tularensis o o o Characteristics n Aerobic n Coccobacillus Location n Water n Intracellular parasite Epidemiology n Zoonotic o Bite mosquito, fly o Tick feces o Infected animal n Rabbit n muskrat n Tularemia Pathogenicity n Capsule n Beta lactamase Disease n LN buboes n Resp: cough, pain n Death

Legionella o Source: environment n n o Epidemiology n n o o Cytotoxic protease Diseases n o Airborne Chronic illness susceptible Path n o Soil Water (A/C, showers) Severe bronchopneumonia Pontiac fever Dx : Isolation, urine Ag Tx: AB Prevention n n clean environment Water chlorination

Legionella pneumophila o Characteristic n n o o Location: water Epidemiology n n o Intracellular parasite Inhalation of aerosols Pathogenicity n n o Aerobic Pleomorphic Protozoa carry Exit pores Disease n n Pneumonia 2 nd: GI, Urinary

Coxiella burnetii o Characteristic n o Location n n o aerobe Intracellular parasite phagolysosome Epidemiology n Hosts o o n o Vector: Tick Pathogenicity n o Avian Mammals Spore like infective body Human Disease n n Inhale infective body Q fever o o Acute Chronic

Pasteurellaceae o Gammaproteobacteria n n o GNR Oxidase (+) FA Nonmotile Groups n n Pasteurella Haemophilus Bovine pneumonia

Pasteurella o o o Characteristics n GNR Agent: P. multocida Location n Normal microbiotica in animals o Oral o Resp Exposure n Animal bite n Aerosol Pathogenesis n Zoonotic Disease n Humans o Abscess o Arthritis n Animals o o Pneumonia Sepsis

Haemophilus o Characteristics n n o Location n o GNR Pleomorphic MM parasite Examples n n n H. influenza H. ducreyi H. aphrophilus H. parainfluenza H. aegyptius

Haemophilus influenzae o Pathogenicity n n n o Disease n n n n o o Capsule K antigen Various strains Meningitis Infantile arthritis Cellulitis Epiglottitis Ocular and Aural (OM) Sinusitis URTI (bronchitis. Pneumonia) Tx: AB Prevention n vaccination

Haemophilus parainfluenza o o Characteristics Epidemiology n o o Pathogenesis Disease n n o Component of dental plaque POD Valvular endocarditis Dx

Haemophilus aegyptius o Purpuric Fever n n n South America Children Disease o o Conjunctivitis N/V/D Shock Death

Haemophilus ducreyi o o STD Pathogenicity n o toxin Disease n Genital ulcer (chancroid)

Vibrios o o o Vibrio Campylobacter Helicobacter

Vibrio o o o o Characteristics n GNR Agent: V. cholera Epidemiology n carriers n Fecal contamination o Water o Food Pathogenesis n Serotypes: O 1 and O 139 n Adhere to intestinal mucosa n Toxin: Choleragen (from bacteriophage) o Subunit A n Activates adenylate cyclase n Hypersecretion of Cl- and H 20 o Subunit B n Binds to intestinal receptors Disease n Muscle cramps n Profuse diarrhea n Circulatory shock and collapse Dx: culture of feces, Agglutination Rxn Tx: supportive; AB Prevention: water sanitation

Proteobacteria o Epsilon n n Campylobacter Helicobacter

Campylobacter o o o Characteristics n GNR, curved n Capnophile Agent: C. jejuni Epidemiology n Source o GI animals n Birds n Cattle o Water n Transmission o Contaminated water o Undercooked food o Contact with infected animals

Campylobacter o o o Pathogenesis n Invades SI n Exotoxin (similar to cholera toxin) Disease n Gastroenteritis and ulceration n Bloody watery diarrhea n Endocarditis n Septic arthritis n Meningitis Dx: Culture and Isolation Tx: Supportive, AB: erythromycin Prevention: n Hygiene n Proper food handling o Pasteurization o Cooking of meat

Helicobacter (Campylobacter) o o o o Characteristics n GNR Agent: H. pylori Epidemiology n Gastric mucosa (mucus) n Food-water: person-person Pathogenesis n Adhesins: Fimbria n Enzymes o Urease o Proteases o Phospholipidase o Cytokines n Toxins: cytoxins Diseases n Gastritis n Peptic ulcers n Gastric cancer Dx: Gastric biopsy culture Tx: n Peptobismol n Metronidizole n Beta lactam AB n Prevacid


Anaerobic GNR o o Bacteroides Prevotella

Bacteroides fragilis o Characteristics n n n o Location n o 85% of GI disease Pathogenicity n n n o Normal GI microbiotica Epidemiology n o GNR Pleomorphic anaerobic Fimbria Capsule Inhibit lysosomes Disease n n n Peritonitis (ruptured GI) Pelvic Abscesses Wound necrosis

Provotella o Characteristic n n o Location: normal flora n n o o Urogenital Respiratory Epidemiology: opportunistic Pathogenicity n n n o GNR anaerobic Adhesins Antiphagocytic capsules Proteases Disease n n Sinusitis OM POD PID

Questions?
- Slides: 78